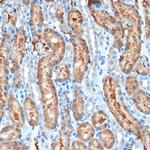
MUC4 Antibody in Immunohistochemistry (Paraffin) (IHC (P))

Search
Invitrogen
MUC4 Recombinant Rabbit Monoclonal Antibody (5J3R7)
{{$productOrderCtrl.translations['antibody.pdp.commerceCard.promotion.promotions']}}
{{$productOrderCtrl.translations['antibody.pdp.commerceCard.promotion.viewpromo']}}
{{$productOrderCtrl.translations['antibody.pdp.commerceCard.promotion.promocode']}}: {{promo.promoCode}} {{promo.promoTitle}} {{promo.promoDescription}}. {{$productOrderCtrl.translations['antibody.pdp.commerceCard.promotion.learnmore']}}
图: 1 / 3
MUC4 Antibody (MA5-42811) in IHC (P)

Please note: We are reviewing Western blot images included in the antibody testing data in our catalog, including those provided by third parties. Unless expressly labeled or annotated as “raw-unedited”, Western blot images included in the antibody testing data in our catalog may have been edited, optimized or otherwise adjusted for presentation.
产品信息
MA5-42811
种属反应
宿主/亚型
Expression System
分类
类型
克隆号
抗原
偶联物
形式
浓度
规格
纯化类型
保存液
内含物
保存条件
运输条件
RRID
产品详细信息
Positive test controls include: HeLa.
Immunogen sequence: WATVSVIALS NILHASASLP PEYQNRTEGL LGVWNNNPED DFRMPNGSTI PPGSPEEMLF HFGMTWQING TGLLGKRNDQ LPSNFTPVFY SQLQKNSSWA EHLISNCDGD
靶标信息
Nearly all mucosal surfaces are protected by mucin transmembrane glycoproteins, from bronchioles to corneas to reproductive tracts. Mucin 4 (MUC4) is membrane-bound and is important in protecting and lubricating. MUC4 expression is erroneous in many carcinomas and sarcomas, including fibromyoxoid sarcoma and pancreatic adenocarcinoma. Immunohistochemical staining for MUC4 has been discussed as a potential biomarker for detection of these cancers. MUC4 seems to be most predominantly affected in Asian diseases - Taiwanese infertility and endometriosis, as well as gallstone formation in Chinese men, are connected to MUC4, where similar diseases in other populations do not share these MUC4 mutations. Because MUC4 is so important in mucosal surface protection, it is not surprising that it has been implicated as failing in many metastatic cancer invasions.
仅用于科研。不用于诊断过程。未经明确授权不得转售。
篇参考文献 (0)
生物信息学
蛋白别名: Ascites sialoglycoprotein; ASGP; ASGP1; MUC-4; Mucin-4; Mucin4; Pancreatic adenocarcinoma mucin; pre-sialomucin complex; sialomucin ascites sialoglycoprotein-1; sialomucin complex; Testis mucin; Tracheobronchial mucin
基因别名: ASGP-1; MUC4; Psmc
Entrez Gene ID: (Rat) 303887




